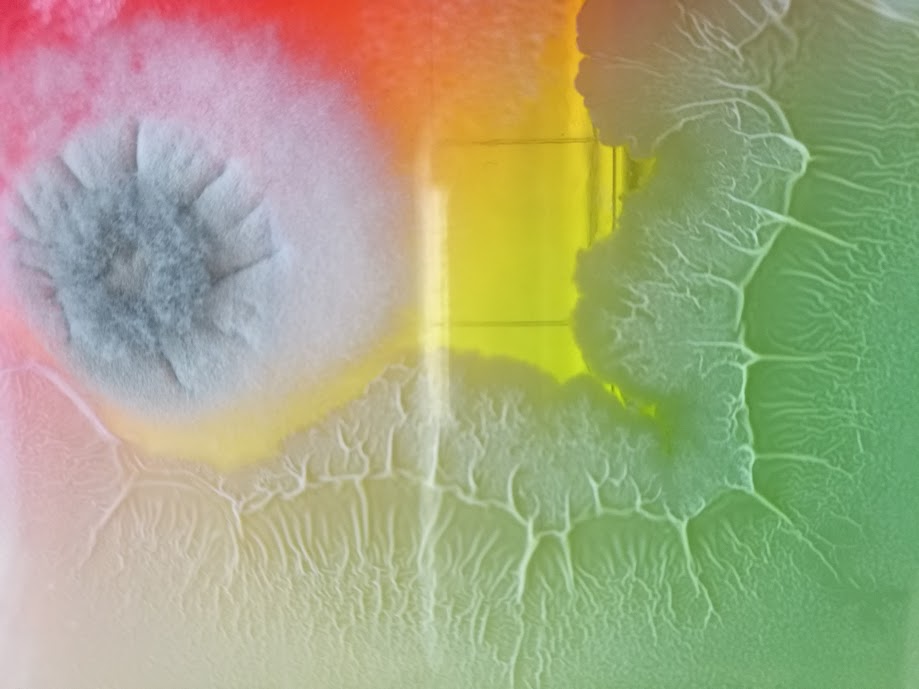

With Planet Earth Observatory, Lynn Fang and I projected a live microscopy performance at the Creepy Crawly Soil Critters event on October 25th, 2024, celebrating the rich diversity of soil critters that thrive in soils tended with organic and regenerative methods of gardening and farming. We are preparing for the second edition this fall, which will take place at the Arlington Garden in Pasadena on November 1st, 2025.

Explore the ghoulish side of life in the soil with fascinating, sometimes horrifying, creatures who have the ability to turn dusty dirt into healthy, life-giving soil. Join us for an engaging evening of storytelling and performance. Wear a costume and get in free. A typewriter poet will be on hand to transform your foggy aspirations into dreamy verse. Yummy treats from the Huntington’s Bon Apetit Cafe. Seeds and other healthy soils giveaways.
For more information about Planet Earth Observatory visit: https://planetearthobservatory.org/